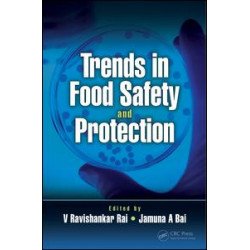
Trends in Food Safety and Protection Trends in Food Safety and Protection

Functional Carbohydrates
This book is a compilation of detailed and latest knowledge on the various types of environmental pollutants released from various natural as well as anthropogenic sources, their toxicological effects in environments, humans, animals and plants as well as various bioremediation approaches for their safe disposal into the environments. In this book, an extensive focus has been made on the various types of environmental pollutants discharged from various sources, their toxicological effects in environments, humans, animals and plants as well as their biodegradation and bioremediation approaches for environmental cleanup.
₹28,977.75